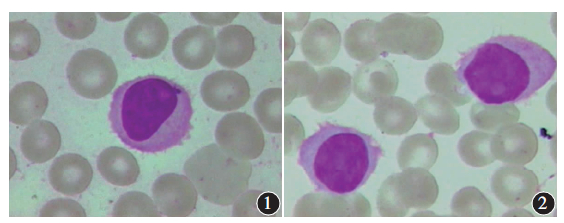

变异型毛细胞白血病一例
文章作者:韩莉莉 陈令松
毛细胞白血病 (HCL)是一种临床罕见的B淋巴细胞增殖性疾病,变异型毛细胞白血病(HCL-V)则更为罕见,约占HCL的10F-20H,占慢性淋巴细胞恶性增殖性疾病的0.4%,国内报道较少。
(HCL)是一种临床罕见的B淋巴细胞增殖性疾病,变异型毛细胞白血病(HCL-V)则更为罕见,约占HCL的10F-20H,占慢性淋巴细胞恶性增殖性疾病的0.4%,国内报道较少。
早期准确诊断HCL-V并给予积极治疗,对改善患者的预后和降低死亡率极为重要。我们回顾性分析我院1例HCL-V患者的临床资料,探讨其诊断依据及鉴别诊断方法,并复习相关文献,现报道如下。
1 病例资料
患者,男,85岁。因发热 、咳嗽
、咳嗽 伴恶心2d于2012年2月4日人住我院呼吸科,经抗感染治疗后发热症状消失,咳嗽及恶心不适减轻。
伴恶心2d于2012年2月4日人住我院呼吸科,经抗感染治疗后发热症状消失,咳嗽及恶心不适减轻。
查体:发现巨脾,外周血象示白细胞计数(WBC)及淋巴细胞比例异常增高,我科会诊考虑“慢性淋巴细胞白血病”,遂于2012年2月18日转人我科继续治疗。仔细询问病史,患者诉脾大 、腹胀20余年未予重视,其间有反复肺部感染病史。
、腹胀20余年未予重视,其间有反复肺部感染病史。
入院查体:无贫血 貌,浅表淋巴结未触及肿大,双肺呼吸音低,左下肺明显,未闻及干湿性啰音,心律齐,心脏各瓣膜区未闻及病理性杂音。
貌,浅表淋巴结未触及肿大,双肺呼吸音低,左下肺明显,未闻及干湿性啰音,心律齐,心脏各瓣膜区未闻及病理性杂音。
腹部平软,肝肋缘下未触及,脾脏大,达脐水平线上1cm,未越过腹正中线,质韧,无压痛,双下肢无水肿 ,生理反射存在,病理反射未引出。
,生理反射存在,病理反射未引出。
入院后进行辅助检查:血常规 :WBC28.99x109/L,血小板(Pit)计数81x109/L,血红蛋白
:WBC28.99x109/L,血小板(Pit)计数81x109/L,血红蛋白 (Hb)133g/L,淋巴细胞百分比73.34%,中性粒细胞百分比24.14%,单核细胞百分比2.64%。
(Hb)133g/L,淋巴细胞百分比73.34%,中性粒细胞百分比24.14%,单核细胞百分比2.64%。
外周血涂片 :白细胞比例明显增高,粒细胞比例减低,淋巴细胞比例增高,染色体
:白细胞比例明显增高,粒细胞比例减低,淋巴细胞比例增高,染色体 细致,可见核仁,胞体边缘不整齐,有不规则绒毛状突起(图1)。
细致,可见核仁,胞体边缘不整齐,有不规则绒毛状突起(图1)。
骨髓细胞学结果示:取材、涂片、染色均良好。骨髓增生活跃,粒系增生减低,淋巴细胞比例增高,部分淋巴细胞边缘不整齐,可见毛状突起(图2)。
免疫分型:淋巴细胞约占有核细胞的53.0%,其中CD19+细胞约占有核细胞的33.7%,表达CD11c、CD19、CD20、CD22,部分细胞表达FMC-7、CD103、Lambda,不表达CD5、CD23和CD25(图3)。
图1 1例变异型毛细胞白血病患者外周血涂片可见毛细胞,细胞表面有多个不规则绒毛状突起瑞特X1000 图2 1例变异型毛细胞白血病患者骨髓血涂片可见不典型毛细胞,细胞边缘不整齐瑞特x1000

图3 1例变异型毛细胞白血病患者免疫分型结果示高表达CD19、CD20、CD11c和CD22等B淋巴细胞免疫标记,部分表达CD103和FMC-7,不表达CD5、CD23和CD25

图4 1例变异型毛细胞白血病患者透射电子显微镜观察可见多个毛细胞,且细胞表面有多个突起,无典型的绒毛结构x4000
淋巴细胞亚群分析结果示:白细胞分类中淋巴细胞比例为84.35%,其中CD3-CD19+细胞占66.32%,粒细胞比例减低(11.51%)。
外周血透射电子显微镜观察结果示:多见绒毛状单个核细胞(图4)。
染色体检查示:46,XY。通过上述辅助检查并结合临床表现,本例患者可明确诊断为HCL-V。经给予重组人干扰素a-2b(300万U,皮下注射,3次/周)维持治疗至今,患者病情有所改善,WBC及淋巴细胞百分比无明显增减,Pit升至正常,脾脏缩小至脐水平线上2cm,未越过中线,提示重组人干扰素'-2b疗效较好。
2 讨论
HCL是一种少见的慢性克隆性B细胞增性疾病,白血病细胞的胞质呈明显的凸起,犹如毛状,故命名为毛细胞。毛细胞主要浸润骨髓及脾脏,临床以脾大、循环血细胞减少为重要征象。
骨髓和外周血中可见具有特异性胞质毛样突起的淋巴细胞,是诊断的重要依据。透射电子显微镜下观察发现毛细胞胞质内常存在核糖体-板层复合结构(RLC),是HCL的另一重要特征,但茹永新 等研究发现中国HCL患者中RLC的阳性率仅为26%,远低于欧洲国家水平,说明RLC作为HCL的电子显微镜诊断标志在国内患者中的特异性不强。
等研究发现中国HCL患者中RLC的阳性率仅为26%,远低于欧洲国家水平,说明RLC作为HCL的电子显微镜诊断标志在国内患者中的特异性不强。
HCL自1958年被Bouron1e首次报道以来,国外已有较多研究,据统计其发病率为0.2/10万〜0.5/10万,约占全部白血病的2%〜5%。HCL多见于中年男性,男女比为4:1,发病的高峰年龄为40〜50岁,病程长短及病情轻重不一致。
HCL-V较经典型HCL(HCL-C)更具侵袭性,多见于老年人,发病中位年龄为71岁,无性别差异,临床特征介于HCL-C和幼淋巴细胞白血病(PLL)之间。2008年世界卫生组织(WHO)不再认为HCL-V是HCL-C的一个亚型,而是把它暂时作为一种独立的疾病。与HCL-C不同,HCL-V对a干扰素及嘌呤核苷酸类似物等传统治疗方法不敏感,预后较差。
HCL-V常以WBC及淋巴细胞比例异常增高,粒细胞及单核细胞比例减低,骨髓干抽为临床特点。因该病较为罕见,误诊率很高。但随着人们对其研究的不断深入,诊断的准确率不断上升。
HCL-V与 HCL-C、脾边缘区B细胞淋巴瘤(SMZL)有相似之处,均有脾大体征,外周血及骨髓均可见毛细胞浸润;免疫分型均表达B淋巴细胞免疫标志M,所以明确三者间的差异,对于提高HCL-V诊断的准确性尤为重要。
HCL-C常表现为白细胞、中性粒细胞及单核细胞减少。HCL-V与SMZL则表现为白细胞增多。细胞形态上,HCL-V细胞与HCL-C和前B淋巴细胞白血病相似,均含有大量的绒毛状突起,胞质呈强嗜碱性,核仁明显,呈圆形或偶尔分叶,染色质致密。
但与SMZL不同,HCL-V细胞胞体较小,核质比例高,核仁明显,呈圆形或椭圆形,细胞抗酒石酸酸性磷酸酶 4TRAP)染色呈阴性或弱阳性。虽然有文献报道仅骨髓细胞形态学诊断HCL的正确率为50M~70%,结合细胞组织化学染色
4TRAP)染色呈阴性或弱阳性。虽然有文献报道仅骨髓细胞形态学诊断HCL的正确率为50M~70%,结合细胞组织化学染色 符合率可提高到90%,免疫分型在该病的鉴别诊断中也发挥着重要作用。
符合率可提高到90%,免疫分型在该病的鉴别诊断中也发挥着重要作用。
HCL-V白血病细胞除表达成熟B细胞免疫标志CD19、CD20、CD22和FMC-7外,还表达CD11c,部分表达CD103,不表达CD10、CD23、CD24、CD25、CD27和CD5。
然而HCL-C细胞高表达CD11c、CD25和CD103,SMZL白血病细胞高表达CD19、CD79b、CD7、CD22,均可与HCL-V相鉴别。另据文献报道HCL-V患者通可见细胞表,面有多个突起,无典型的绒毛结构;而在HCL-C患者中,常可见毛细胞表面突起密集,成为HCL-C细胞形态的标志。
本例患者有脾大、反复肺部感染病史,血常规示WBC及淋巴细胞比例异常增高,外周血涂片及骨髓细胞学检查均可见淋巴细胞比例明显增高,核仁明显,胞体边缘不整齐,有不规则绒毛状突起。
免疫分型表达CD11c、CD19、CD20、CD22,部分细胞表达FMC-7、CD103、Lambda。外周血透射电子显微镜观察多见绒毛状单个核细胞,均符合HCL-V的表现。
因此,临床上诊断HCL-V时,除了需要观察外周血及骨髓形态,还需要结合免疫分型及透射电子显微镜结果进行鉴别诊断,以提高HCL-V诊断的准确率。
白血病.淋巴瘤2014 年3月23卷3期
